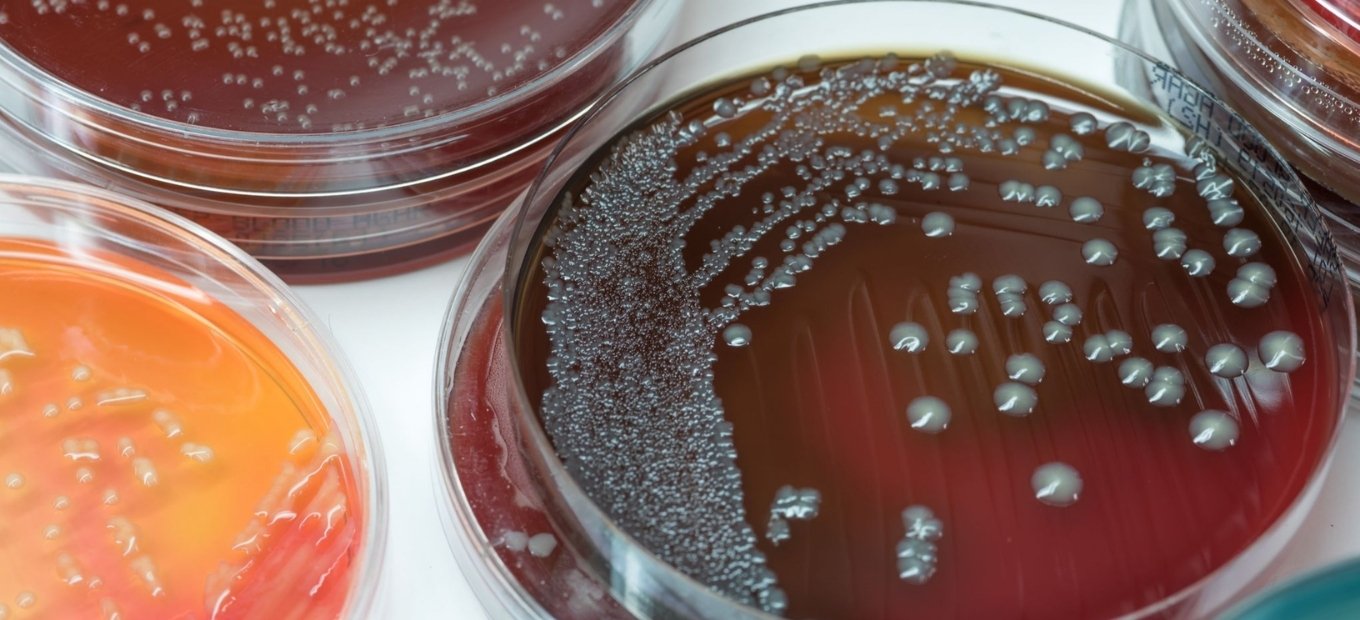

Schulke & Mayr
Octenisan®
Octenisan linija proizvoda uključuje proizvode na bazi oktenidina namijenjene za pranje i dekolonizaciju kože i kose nepokretnih bolesnika u kućnom i bolničkom okruženju.
Proizvodi iz ove linije prikladni su za primjenu i u jedinicama intenzivnog liječenja.

Više o brendu
Octenisan®
Klikom na odabrani proizvod otvara se mogućnost online kupnje.

Primjena
Indikacijska područja primjene Octenisan® proizvoda

Vlaženje sluznice nosa
Octenisan® MD gel za nos koristi se kao potporna terapija u liječenju oštećenja sluznice nosa. Osim što vlaži sluznicu nosa, ima i antiseptički učinak koji osigurava uništavanje mikroorganizama na njezinoj površini.
Njegovo djelovanje se temelji na tri spoja:
- propilen glikol – primjer je spoja koji se koristi za rješavanje suhoće i nadraženosti sluznice nosa. Svojom strukturom pridonosi vlaženju sluznice nosa, pomaže u rješavanju problema guste sluzi, olakšava disanje i sprječava pojavu krvarenja iz nosa.
- hidroksietil celuloza – polimer topljiv u vodi koji na sebe veže molekule vode. Često se koristi kako bi se osigurala konzistencija gela, a svoju primjenu nalazi i u izradi umjetnih suza.
- oktenidin – djelatna tvar kojoj je svojstven širok antiseptički spektar djelovanja (baktericidan, fungicidan i ograničen virucidan učinak).

Njega nepokretnog bolesnika
Octenisan® rukavice za pranje su jednokratne rukavice impregnirane antiseptikom oktenidinom, namijenjene čišćenju i njezi kože.
Octenisan® kapa za pranje je jednokratna kapa impregnirana antiseptikom oktenidinom namijenjena pranju kose i vlasišta.
Dekolonizacija nosne šupljine provodi se s Octenisan® MD gelom za nos.
Uz Octenisan liniju proizvoda, kod nepokretnih bolesnika može poslužiti i Octenident® otopina za ispiranje usta kojom se održava higijena usne šupljine.

Dekolonizacija u bolničkim uvjetima
Kako bi se spriječila endogena bolnička infekcija i mogućnost postoperativne infekcije svela na najmanju moguću mjeru, bolesnici se podvrgavaju dekolonizaciji cijelog tijela. Njezina svrha je smanjiti pojavnost bolničkih infekcija, smanjiti uporabu antibiotika, poboljšati sigurnost bolesnika i smanjiti troškove praćenja i skrbi.
Proizvodi za dekolonizaciju na bazi oktenidina
- Octenisan® losion za pranje namijenjen je za dekolonizacija kože, vlasišta i kose.
- Za provođenje dekolonizacije nosne šupljine koristi se Octenisan® MD gel za nos dva puta dnevno tijekom pet dana.
- Kod nepokretnih bolesnika koristi se posebno dizajnirana Octenisan® kapa za pranje tjemena i vlasišta.
- Octenisan® rukavice za pranje namijenjene su dekolonizaciji i pranju tijela nepokretnih osoba.

Dekolonizacija prije operacije
Cilj preoperativne dekolonizacije bolesnika je uklanjanje potencijalno opasnih mikroorganizama i izbjegavanje razvoja postoperativne infekcije.
Dekolonizacija bolesnika obuhvaća kombinaciju aseptičkog pranja cijelog tijela i dekolonizaciju nosne šupljine.
Preoperativno pranje tijela i kose. Preporuča se kroz pet dana prije operacije jednom dnevno istuširati se s Octenisan® losionom za pranje na bazi oktenidina, a vlasište i kosu oprati dva puta (u dva navrata) tijekom pet dana pripreme (losion se nanosi na kožu i kosu nerazrijeđen i ostavi djelovati jednu minutu).
Preoperativna dekolonizacija nosa. Provodi se s Octenisan® MD gelom za nos na bazi oktenidina dva puta dnevno tijekom pet dana prije termina operacije.

Oktenidin
Prednosti oktenidina kao antiseptika
Sredinom osamdesetih godina dvadesetog stoljeća razvijen je oktenidin, djelatna tvar antiseptičkih svojstava, koja je danas postala standard u liječenju i zbrinjavanju rana.
Svojstven mu je širok antimikrobni spektar djelovanja – pokazuje baktericidan (ubija bakterije), fungicidan (ubija gljivice) i ograničen virucidan (ubija viruse) učinak. Djeluje unutar jedne minute od primjene uz dugotrajan učinak i do 24 sata. Bezbojan je, bezbolan i niskih alergijskih svojstava, stoga je dobro podnošljiv na koži, sluznici i tkivu.
Prikladan je za primjenu kod djece, dojenčadi i nedonoščadi.
Kako djeluje oktenidin
U potrazi za djelotvornim i podnošljivim antiseptikom za usnu sluznicu, istraživači su polovicom osamdesetih godina prošloga stoljeća sintetizirali pozitivno nabijenu molekulu te dobili inovativnu djelatnu tvari oktenidindiklorid (skraćeno oktenidin) koja je postala predstavnica novog razreda djelatnih tvari - bispiridina. Time je počeo trijumf novog antiseptika tvrtke Schϋlke & Mayr, čiji je vlastiti istraživački tim nastavio razvijati ovaj lijek.
Povezani članci
Vaše zdravlje - vodič za zdraviji život

Antimikrobna izvrsnost oktenidina
Oktenidini zadovoljavaju brojne kriterije koji se traže od dobrog antiseptika i korisnici ih prihvaćaju u visokom postotku.

Suhoća nosne sluznice
Isušivanju nosne sluznice pogoduje klimatizirani prostor, prekomjerna upotreba nazalnih dekongestiva, izloženost prašini i duhanskom dimu te starija životna dob.
Zlatni strafilokok
Među nesporogenim bakterijama stafilokoki su najotporniji na nepovoljne uvjete okoline, no osjetljivi su na sve dezinficijense.

Pranje ruku doprinosi prevenciji bolesti
Mnoga istraživanja pokazuju da se redovitim i pravilnim pranjem ruku broj mikroorganizama može smanjiti od 100 do 1000 puta, što pridonosi prevenciji zaraznih bolesti.

